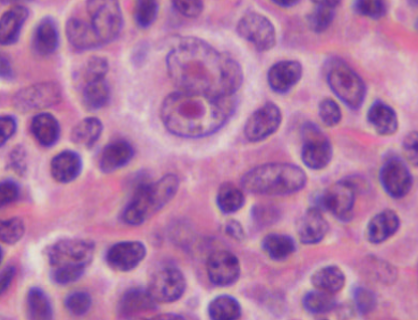
knowt flashcard image
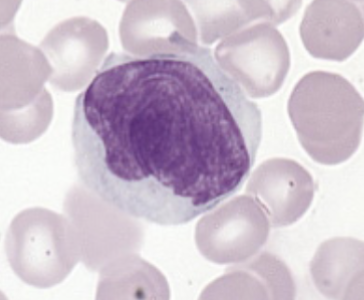
knowt flashcard image
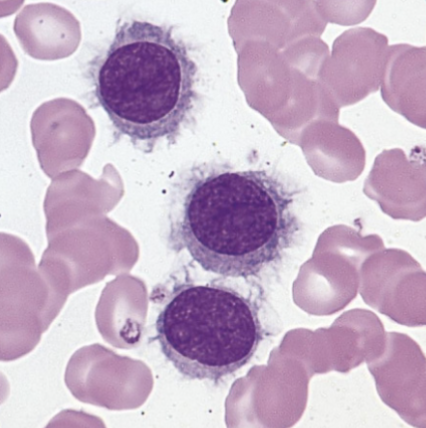
knowt flashcard image
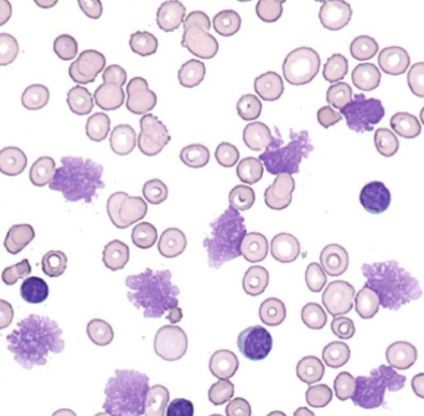
knowt flashcard image

mature lymphoid neoplasms chapter 34
1/28
There's no tags or description
Looks like no tags are added yet.
Name | Mastery | Learn | Test | Matching | Spaced | Call with Kai |
|---|
No analytics yet
Send a link to your students to track their progress
29 Terms
primary site of disease for leukemias
blood or bone marrow
primary site of disease for lymphomas
lymph nodes or spleen
what is the gold standard for lymphona diagnosis
excisional biopsy
what is the most common leukemia in adults in western countries
chronic lymphocytic leukemia
chronic lymphocytic leukemia (CLL) morphology
smudge cells (basket cells)
which protein can you add to help preserve the lymphocyte cell wall from rupturing
albumin
B cell phenotyping
CD19 + CD20
prolymphocytic leukemia (PLL) characteristic
>50% prolymphocytes
hairy cell leukemia characteristics
small B lymphs with abundant cytoplasm and fine ‘hairy’ cytoplasmic projections
which stain is specific for HCL
TRAP stain(tartrate resistant acid phosphate)
burkitt lymphoma/leukemia characteristic
basophilic cytoplasm with distinct vacuoles (starry night)
mycosis fungoides (MF)/sezary syndrome is a ___ lymphoma
T cell
most common form of cutaneous T cell lymphoma
MF
MF/SS morphology
cerebral formed nucleus
anaplastic large cell lymphoma is a ___ disorder
T cell
monoclonal gammopathy of undetermined significance (MGUS) is ___
benign
multiple myeloma (MM) characteristics
>70% plasma cells in bone marrow, bence jones protein positive
MM peripheral blood morphology
rouleaux
which immunoglobulin is elevated in MM
IgG
which immunoglobulin is elevated in waldenstrom’s macroglobulinemia
IgM
what is an M spike
a spike in the gamma region in protein electrophoresis
hodgkins lymphoma (HL) affects which age group
young adults
HL morphology
reed sternberg cells, ‘owl eye’
hodgkins lymphoma
multiple myeloma bone marrow

mycosis fungoides/sezary syndrome MF/SS
burkitt lymphoma/leukemia (BL)

hairy cell leukemia (HCL)
chronic lymphocytic leukemia (CLL)